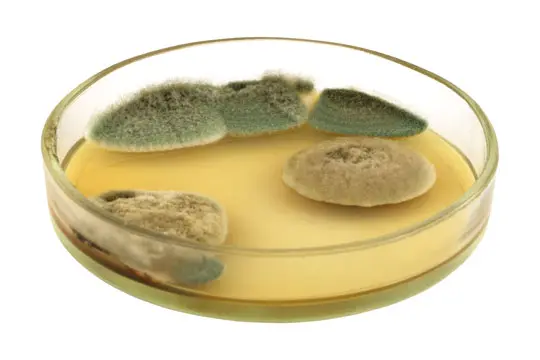
Složka granulí

Trichoderma
Trichoderma (trichoderma longibrachiatum) je houba, která je schopná chránit hostitelskou rostlinu před choroboplodnými houbami (patogeny). Využívá se při výrobě biopaliv (schopná rozkládat celulózu) a používá se k výrobě cyklosporinu, léčiv na potlačení imunity.
Její obyčejná forma se nachází např. ve vzduchových filtrech nebo v rozích oken.
Do krmiv pro psy se přidává pravděpodobně kvůli ochraně před plísněmi a baktériemi. Některé zdroje uvádějí, že dokáže vyčistit těžké kovy.
Zvažte, zda chcete krmit psa „houbami", proti kterým v domácnosti bojujete dezinfekcí, nebo raději vyberete krmivo, které tyto látky vůbec neobsahuje.
Pozor! Stále jde o houbu, která se na rostlině sama chová jako parazit a vlastně jen likviduje svou přirozenou konkurenci. Trichoderma longibrachiatum je silný alergen, který může vyvolat alergickou reakci.